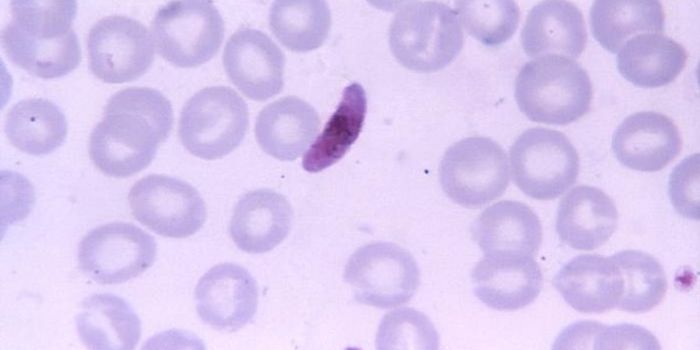
Novel Method to Suppress Malaria Parasite's Virulence Genes

RNA regulation
mRNA contain a riboswitch which allows for self-regulation by binding to a target molecule. RNA regulation occurs in response to concentrations of target molecule allowing control of gene expression. Riboswitches are most common in bacteria, plants, and fungi.
-
MAY 14, 2015Genetics & GenomicsUnderstanding the function of certain groups of non-coding RNAs will lead to a greater understanding of how certain illn ...Written By: Ilene SchneiderAPR 27, 2015Cell & Molecular BiologyCaltech researchers have found how an abundant class of RNA genes-called long non-coding RNAs (lncRNAs, pronounced link ...Written By: Judy O'RourkeAPR 22, 2015Genetics & GenomicsCould the epigenome provide a new avenue for gene therapies and guiding stem cell differentiation?
Written By: Robert WoodardAPR 06, 2015CancerNorthwestern Medicine scientists have identified a small RNA molecule called miR-182 that can suppress cancer-causing ge ...Written By: Ilene SchneiderAPR 06, 2015Genetics & GenomicsGrowing up near Springfield, Mass., Laurie Boyer was always interested in science but didn't have many opportunities to ...Written By: Ilene SchneiderAPR 06, 2015CancerMost of today's anticancer drugs target the DNA or proteins in tumor cells, but a new discovery by University of Califor ...Written By: Robert WoodardMAR 26, 2015Genetics & GenomicsJust as two DNA strands naturally arrange themselves into a helix, DNA's molecular cousin RNA can form hairpin-like loop ...Written By: Judy O'RourkeMAR 20, 2015NeuroscienceA research team at UC San Francisco has discovered an RNA molecule called Pnky that can be manipulated to increase the p ...Written By: Ilene SchneiderMAR 17, 2015ImmunologyResearchers at the University of Arizona have discovered what causes and regulates collective cell migration, one of the ...Written By: Ilene SchneiderMAR 16, 2015Cell & Molecular BiologyResearchers at the University of Arizona have discovered what causes and regulates collective cell migration, one of the ...Written By: Brenda Kelley KimMAR 12, 2015Cancer
A study by University of Illinois at Chicago researchers aims to determine whether green tea can inhibit the growt ...Written By: Robert WoodardFEB 25, 2015MicrobiologyUp to one million people -- mainly pregnant woman and young children -- are killed each year by the Plasmodium falciparu ...Written By: Judy O'RourkeFEB 24, 2015Genetics & GenomicsThere are some 1,900 locations in the human genome that produce microRNAs (miRNAs), the small and powerful non-coding mo ...Written By: Judy O'RourkeFEB 17, 2015Genetics & GenomicsThe gradual modification of a species' structures and features, otherwise known as the principle of adaptation, is one o ...Written By: Ilene SchneiderSEP 17, 2014Health & MedicineThe star of laboratory-developed tests (LDTs) has long been on the rise. From diabetes, to cancer, to an obscure genetic ...Written By: Judy O'RourkeJUL 14, 2014VideosRNA interference (RNAi) is an important process, used by many different organisms to regulate the activity of genes. Thi ...Written By: Robert WoodardAPR 08, 2013VideosRNA interference (RNAi) is an important process, used by many different organisms to regulate the activity of genes. Thi ...Written By: Jennifer Ellis
MAY 14, 2015
Genetics & Genomics
Understanding the function of certain groups of non-coding RNAs will lead to a greater understanding of how certain illn
...
Written By:
Ilene Schneider
APR 27, 2015
Cell & Molecular Biology
Caltech researchers have found how an abundant class of RNA genes-called long non-coding RNAs (lncRNAs, pronounced link
...
Written By:
Judy O'Rourke
APR 22, 2015
Genetics & Genomics
Could the epigenome provide a new avenue for gene therapies and guiding stem cell differentiation?
Written By:
Robert Woodard
APR 06, 2015
Cancer
Northwestern Medicine scientists have identified a small RNA molecule called miR-182 that can suppress cancer-causing ge
...
Written By:
Ilene Schneider
APR 06, 2015
Genetics & Genomics
Growing up near Springfield, Mass., Laurie Boyer was always interested in science but didn't have many opportunities to
...
Written By:
Ilene Schneider
APR 06, 2015
Cancer
Most of today's anticancer drugs target the DNA or proteins in tumor cells, but a new discovery by University of Califor
...
Written By:
Robert Woodard
MAR 26, 2015
Genetics & Genomics
Just as two DNA strands naturally arrange themselves into a helix, DNA's molecular cousin RNA can form hairpin-like loop
...
Written By:
Judy O'Rourke
MAR 20, 2015
Neuroscience
A research team at UC San Francisco has discovered an RNA molecule called Pnky that can be manipulated to increase the p
...
Written By:
Ilene Schneider
MAR 17, 2015
Immunology
Researchers at the University of Arizona have discovered what causes and regulates collective cell migration, one of the
...
Written By:
Ilene Schneider
MAR 16, 2015
Cell & Molecular Biology
Researchers at the University of Arizona have discovered what causes and regulates collective cell migration, one of the
...
Written By:
Brenda Kelley Kim
MAR 12, 2015
Cancer
A study by University of Illinois at Chicago researchers aims to determine whether green tea can inhibit the growt ...
Written By:
Robert Woodard
FEB 25, 2015
Microbiology
Up to one million people -- mainly pregnant woman and young children -- are killed each year by the Plasmodium falciparu
...
Written By:
Judy O'Rourke
FEB 24, 2015
Genetics & Genomics
There are some 1,900 locations in the human genome that produce microRNAs (miRNAs), the small and powerful non-coding mo
...
Written By:
Judy O'Rourke
FEB 17, 2015
Genetics & Genomics
The gradual modification of a species' structures and features, otherwise known as the principle of adaptation, is one o
...
Written By:
Ilene Schneider
SEP 17, 2014
Health & Medicine
The star of laboratory-developed tests (LDTs) has long been on the rise. From diabetes, to cancer, to an obscure genetic
...
Written By:
Judy O'Rourke
JUL 14, 2014
Videos
RNA interference (RNAi) is an important process, used by many different organisms to regulate the activity of genes. Thi
...
Written By:
Robert Woodard
APR 08, 2013
Videos
RNA interference (RNAi) is an important process, used by many different organisms to regulate the activity of genes. Thi
...
Written By:
Jennifer Ellis